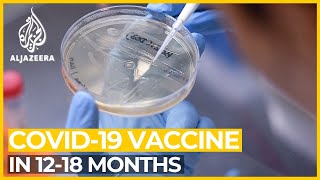

COVID 19 vaccine could be ready in 12 18 months: US top scientist Fauci video
Online izle ve mp4 mp3 formatlarinda yukle

Videonun muddeti: 7:03
COVID 19 vaccine could be ready in 12 18 months: US top scientist Fauci videosu mp4 ve mp3 yuklemek ucun hazirdir
Diqqet! Siz Mp4 yukle ve ya Mp3 yukle duymesine basdiqdan sonra eger sistem sizi reklam sehifesine atarsa o zaman derhal geri qayidib emeliyyati tekrar edin ve faylin yuklemek ucun hazir olmasini gozleyin
Videodan Mp4 Yukle
Videodan Mp3 Yukle-1
Videodan Mp3 Yukle-2
Oxshar Axtarishlar
 COVID-19 vaccine could be ready in 12-18 months: US top scientist Fauci
COVID-19 vaccine could be ready in 12-18 months: US top scientist Fauci US health official says COVID 19 vaccine could take 18 months to develop
US health official says COVID 19 vaccine could take 18 months to develop Ask Dr. Fauci: mRNA COVID-19 Vaccines
Ask Dr. Fauci: mRNA COVID-19 Vaccines WATCH: COVID-19 vaccine could be available to Americans by end of 2020 or start of 2021, Fauci says
WATCH: COVID-19 vaccine could be available to Americans by end of 2020 or start of 2021, Fauci says When will we have a coronavirus vaccine?
When will we have a coronavirus vaccine? Fauci says U.S. could have COVID under control by spring 2022 if vaccination picks up
Fauci says U.S. could have COVID under control by spring 2022 if vaccination picks up Fauci reveals what happened after correcting Trump at 2020 Covid briefing
Fauci reveals what happened after correcting Trump at 2020 Covid briefing Dr. Anthony Fauci Answers Questions on Covid-19 Vaccines, Lockdowns, Masks and More
Dr. Anthony Fauci Answers Questions on Covid-19 Vaccines, Lockdowns, Masks and More Dr. Anthony Fauci on a vaccine timetable and reaching out to anti-vaxxers
Dr. Anthony Fauci on a vaccine timetable and reaching out to anti-vaxxers
Video Mp4 Mp3Azwap.Biz
Azwap.Biz 2021-2023

COVID-19 vaccine could be ready in 12-18 months: US top scientist Fauci
COVID-19 vaccine could be ready in 12-18 months: US top scientist Fauci US health official says COVID 19 vaccine could take 18 months to develop
US health official says COVID 19 vaccine could take 18 months to develop Ask Dr. Fauci: mRNA COVID-19 Vaccines
Ask Dr. Fauci: mRNA COVID-19 Vaccines WATCH: COVID-19 vaccine could be available to Americans by end of 2020 or start of 2021, Fauci says
WATCH: COVID-19 vaccine could be available to Americans by end of 2020 or start of 2021, Fauci says When will we have a coronavirus vaccine?
When will we have a coronavirus vaccine? Fauci says U.S. could have COVID under control by spring 2022 if vaccination picks up
Fauci says U.S. could have COVID under control by spring 2022 if vaccination picks up Fauci reveals what happened after correcting Trump at 2020 Covid briefing
Fauci reveals what happened after correcting Trump at 2020 Covid briefing Dr. Anthony Fauci Answers Questions on Covid-19 Vaccines, Lockdowns, Masks and More
Dr. Anthony Fauci Answers Questions on Covid-19 Vaccines, Lockdowns, Masks and More Dr. Anthony Fauci on a vaccine timetable and reaching out to anti-vaxxers
Dr. Anthony Fauci on a vaccine timetable and reaching out to anti-vaxxers